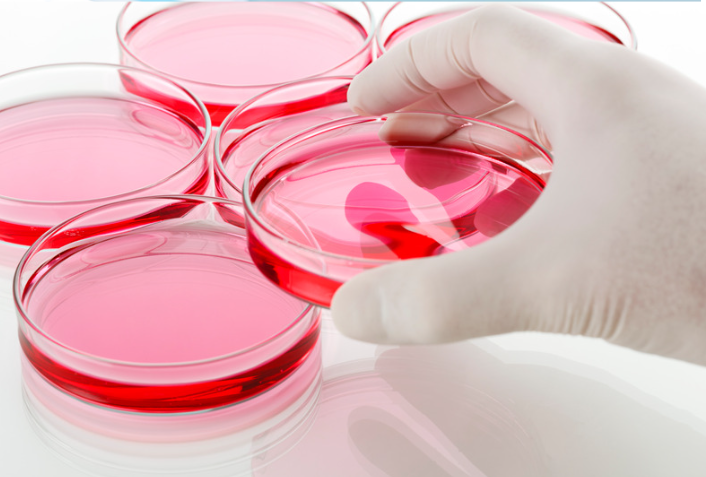

Nagano’s secret: The 11-1 Probiotic Discovery
In the serene landscapes of Nagano, a place where tradition intertwines seamlessly with the rhythms of nature, a discovery was made that would bridge ancient wisdom with modern health.
Within a modest dwelling, celebrated for its unwavering commitment to the time-honored technique of 'nuka'—a fermented rice bran concoction integral to pickling practices—a remarkable strain of lactic acid bacteria was discovered. This strain, meticulously nurtured through generations of routine culinary practices, was unveiled to possess the secret to extraordinary health benefits.
Cultivating a Rare Gem
The challenge of cultivating Lactobacillus 11-1 was monumental, requiring a recreation of its unique natural habitat found only in Nagano. This endeavor highlighted the bacterium's delicate nature and the extraordinary lengths researchers went to in order to unlock its potential, emphasizing its rarity and the delicate balance required to harness its health benefits.

Tradition Meets Cutting-Edge Science
At the Faculty of Pharmaceutical Sciences, University of Tokyo, scientists delved into this strain, identified as Lactobacillus 11-1, using advanced techniques to measure its immune-stimulating capabilities. Their research, leveraging patented technology to analyze the immunostimulatory activity rate using silkworms, established Lactobacillus 11-1's superior potential among thousands of tested substances, setting a new benchmark in probiotic efficacy.
Redefining Probiotic Potential
Unveiling the efficacy of killed bacteria, the story of Lactobacillus 11-1 takes an intriguing turn. Contrary to the common perception that probiotics must be alive to be beneficial, this special strain retains its health-promoting properties even after being heat-treated. This revelation not only highlights the robustness of Lactobacillus 11-1 but also underscores a broader understanding of probiotic potential beyond living cultures.
The Science of Killed Bacteria
The science behind this phenomenon is as fascinating as it is groundbreaking. Heat-treated Lactobacillus 11-1 bacteria maintain their cellular structure, which can still activate the body's immune response. This interaction bolsters the immune system, offering a layer of protection and health benefits without the complexities and risks associated with live bacterial cultures. It's a testament to the sophisticated balance between nature's designs and scientific innovation.
Combatting Resistant Infections
-
A Breakthrough in Immunotherapy
The research conducted by the Faculty of Pharmaceutical Sciences, University of Tokyo, shed light on how Lactobacillus 11-1 could significantly enhance the body's ability to fight off infections, particularly those caused by drug-resistant strains of bacteria. In laboratory tests involving silkworms, a model organism susceptible to human pathogens, Lactobacillus 11-1 showed remarkable efficacy in preventing death from infections by Pseudomonas aeruginosa, a notorious bacterium known for its resistance to multiple antibiotics.
-
Implications for Human Health
These findings suggest a promising avenue for immunotherapy, leveraging the body's own mechanisms to combat infections that current drugs struggle to treat. By enhancing the immune response, Lactobacillus 11-1 may help reduce the reliance on antibiotics and provide a sustainable alternative in the fight against resistant infections. This approach not only has the potential to save lives but also to curb the rising tide of antibiotic resistance, preserving the efficacy of existing drugs for future generations.
A New Era of Wellness
In integrating killed Lactobacillus 11-1 into our probiotics, we harness the full spectrum of its health-enhancing properties in a form that is both powerful and practical. This method embodies the synergy of traditional fermentation wisdom with the precision of contemporary science, providing a supplement that supports not just gut health but overall well-being. Thus, the journey of Lactobacillus 11-1 from the nurturing hands of Nagano's traditional 'nuka' practitioners to the forefront of health science encapsulates a story of innovation, tradition, and the relentless pursuit of wellness.